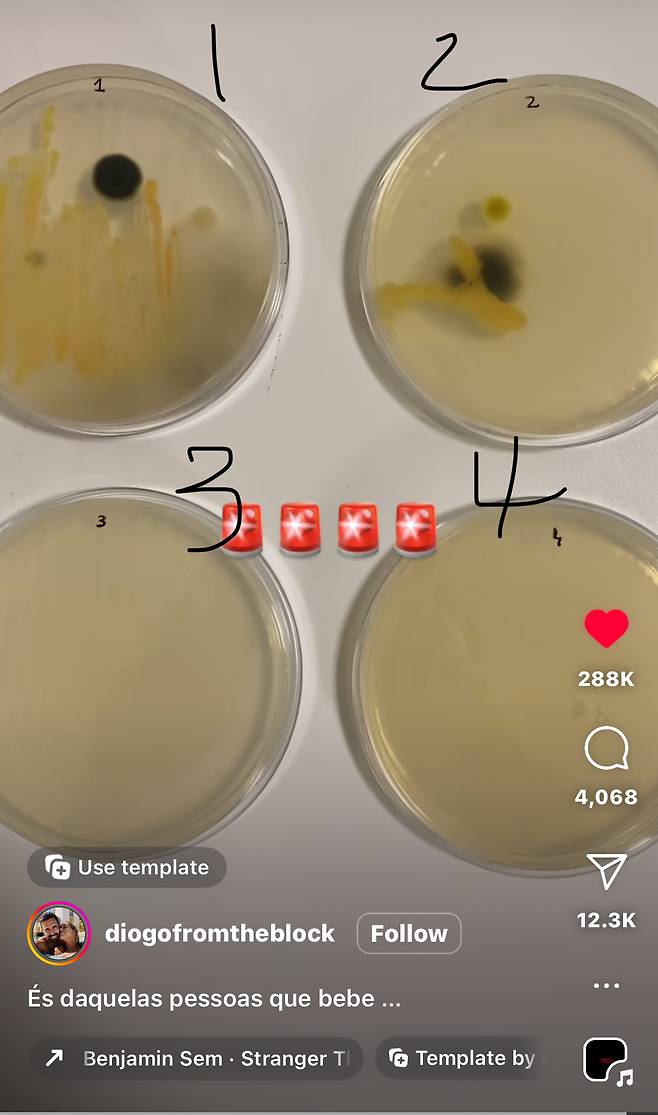
sFYKIS

https://www.instagram.com/p/CzedJ4xMaRj/?igshid=MzY1NDJmNzMyNQ==
박테리아 배양검사 결과

1번 안 닦은 캔
2번 옷으로 닦은 캔
3번 키친타올(마른 휴지)로 닦은 캔
4번 70% 에탄올에 적신 티슈로 닦은 캔
원덬이 방금 대충 소매로 빡빡 닦고 제로콜라 마셨다가
궁금해져서 찾아봤다가 나만 볼 수 없어서 가져옴ㅠㅠ
면역력 약해지는 시기니까 꼭꼭 깨끗하게 닦아서 마시자!
https://www.instagram.com/p/CzedJ4xMaRj/?igshid=MzY1NDJmNzMyNQ==
박테리아 배양검사 결과
1번 안 닦은 캔
2번 옷으로 닦은 캔
3번 키친타올(마른 휴지)로 닦은 캔
4번 70% 에탄올에 적신 티슈로 닦은 캔
원덬이 방금 대충 소매로 빡빡 닦고 제로콜라 마셨다가
궁금해져서 찾아봤다가 나만 볼 수 없어서 가져옴ㅠㅠ
면역력 약해지는 시기니까 꼭꼭 깨끗하게 닦아서 마시자!